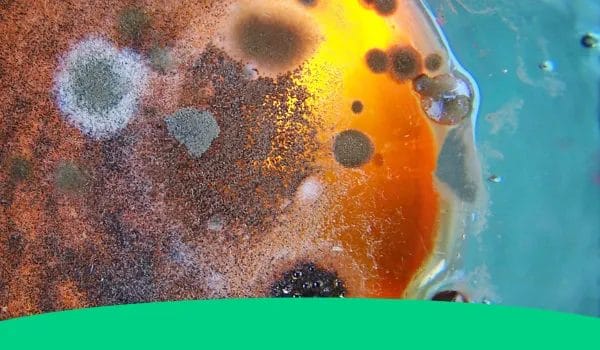
2. understanding mold growth

Can Reusable Bamboo Straws Get Moldy?
Learn the answer to the most common question about bamboo straws, can they get moldy?
Have you jumped on the eco-friendly trend of using bamboo straws? These eco-friendly alternatives to single-use plastic straws are becoming increasingly popular among environmentally conscious consumers. However, one question that often arises is whether or not bamboo straws can get moldy.
Bamboo straws are a great alternative to single-use plastics as they are sustainable and biodegradable. They are also easy to clean and reusable, making them a perfect option for those who want to reduce their environmental impact.
However, like any reusable item, bamboo straws require proper maintenance and care to keep them in good condition. In this article, we will explore whether or not bamboo straws can get moldy and how you can prevent it from happening.
Can Bamboo Straws Get Moldy?
The short answer is yes, but there are ways to prevent it from happening. When it comes to using bamboo straws, proper care is essential to ensure their longevity and hygienic use. After each use, rinse the straw with water and let it dry completely before storing it away.
Get Your Hand on Your Eco-Friendly Living Starter Guide!
Additionally, once a week or as needed, clean the straw by soaking it in vinegar and water solution for about 10 minutes before rinsing it with water again. This will not only help prevent mold growth but also keep the straw clean and fresh for future use.
As a sustainable and biodegradable alternative to plastic straws, bamboo straws offer an eco-friendly option for those looking to reduce their environmental impact. By following these simple care tips, you can enjoy using your bamboo straws while keeping them free from mold and other unwanted growths.
Understanding mold growth is crucial when caring for your bamboo straws. In the next section, we’ll explore what causes mold to grow and how you can take preventative measures against it.
Understanding Mold Growth
If you’re worried about your bamboo straw getting moldy, the good news is that it’s not likely to happen if you take care of it properly. However, if you don’t clean your straw regularly or leave it wet for long periods of time, mold can grow on the inside of the straw.
This can be both unsightly and unhygienic, so it’s important to know how to prevent mold growth. To keep your bamboo straw clean and mold-free, rinse it with hot water after every use and let it dry completely before storing it.
If you notice any discoloration or odor inside the straw, clean it with a mixture of vinegar and soapy water. For a deeper clean, boil the straw in water for a few minutes. By taking these simple steps, you can ensure that your bamboo straw remains both sustainable and hygienic.
Factors That Contribute To Mold Growth
Factors that Contribute to Mold Growth:
Mold can grow in many different environments and on various materials, including bamboo straws. If left uncleaned or improperly stored, mold can quickly develop inside of the straw, making it unsanitary and potentially harmful to use.
Several factors can contribute to the growth of mold inside bamboo straws, such as:
- Moisture: When bamboo straws are not thoroughly dried after use or cleaning, moisture can accumulate and create a suitable environment for mold to grow.
- Temperature: Warm temperatures promote mold growth, so if bamboo straws are stored in a warm and humid location, they are more likely to develop mold.
- Lack of airflow: Without proper ventilation, air cannot circulate through the straw effectively. This lack of airflow can cause moisture buildup and encourage mold growth.
- Dirty conditions: If the bamboo straw is not cleaned properly or regularly, bacteria and other microorganisms can multiply and potentially lead to mold growth.
- Improper storage: Storing damp or dirty bamboo straws in an enclosed container or bag can create a breeding ground for mold.
To avoid potential health risks associated with using a moldy bamboo straw, it is essential to keep them clean and dry. While sustainable alternatives like bamboo straws offer eco-friendly benefits over disposable plastic options, proper care is necessary for longevity.
Below are some tips on how to clean your bamboo straws:
- Rinse your bamboo straw with hot water after each use
- Use a cleaning brush to remove any leftover debris
- Soak your straw in vinegar or boiling water for 10 minutes once a week
- Air-dry your bamboo straw completely before storing it
- Store your dry bamboo straw in an open container with good airflow
Preventing mold growth on bamboo straws starts with regular maintenance and proper storage. By following these simple steps, you can ensure that your eco-friendly alternative remains hygienic for daily use.
Preventing Mold Growth On Bamboo Straws

Bamboo straws are a sustainable alternative to plastic straws, but they are not immune to mold growth. Mold can grow on bamboo straws if they are not properly cleaned and maintained. This can be a health concern as mold can cause respiratory problems and allergies.
However, with proper care, it is possible to prevent mold growth on bamboo straws. To prevent mold growth, it is important to clean bamboo straws regularly. Rinse them out with warm water immediately after use and allow them to air dry completely before storing them.
If you notice any signs of mold on your bamboo straw, do not panic. Simply soak the straw in vinegar for a few minutes, then rinse it thoroughly with warm water. Vinegar is an effective antimicrobial agent that will kill any mold spores and keep your bamboo straw hygienic. Once the straw is clean, let it dry completely before using or storing it again.
When cleaning and maintaining bamboo straws, there are several steps you can take to ensure their longevity and hygiene. By following these simple steps, you can enjoy your sustainable and compostable bamboo straws for years to come without worrying about mold growth or other health concerns.
Cleaning And Maintaining Bamboo Straws

Bamboo straws are a popular eco-friendly alternative to plastic straws. They are reusable, sustainable, and biodegradable.
However, if not properly cleaned and maintained, they can get moldy. Mold is a common problem for bamboo straws because of the moisture that accumulates in them after use.
To prevent mold growth, it is important to clean your bamboo straw regularly. You can rinse it with warm water after each use to remove any residue or debris. For a deeper clean, you can soak the straw in a mixture of water and vinegar for a few hours. Vinegar is a natural disinfectant that helps kill bacteria and fungi. Alternatively, you can boil the straw in water for a few minutes to sanitize it.
Make sure to let the straw dry completely before using it again. Avoid using harsh detergents or cleaning agents as they may damage the bamboo material.
Maintaining your bamboo straw is essential in keeping it mold-free and extending its lifespan. Store your bamboo straw in a dry place away from direct sunlight or heat sources. Avoid leaving the straw wet or damp for extended periods, as this creates an environment conducive to mold growth.
With proper cleaning and maintenance, your bamboo straw can last several months while being an eco-friendly alternative to single-use plastic straws.
Conclusion on Reusable Bamboo Straws
So, can bamboo straws get moldy?
The answer is yes. However, with proper care and maintenance, the likelihood of mold growth can be significantly reduced.
Understanding the factors that contribute to mold growth on bamboo straws and taking the necessary steps to prevent it can help ensure that your eco-friendly alternative to plastic straws remains safe and hygienic for use.
By regularly cleaning and maintaining your bamboo straws, you can avoid any unpleasant surprises when it comes time to enjoy your favorite drink.
So go ahead and sip away with confidence, knowing that your bamboo straw is free from mold!
